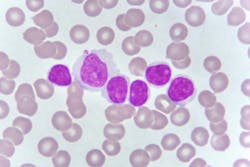
65d60fd54df9a8001e895913 Dreamstime Xxl 114072009 65d60fd54df9a8001e895913 Dreamstime Xxl 114072009

Targeting treatment resistance in chronic lymphocytic leukemia
New research from Sylvester Comprehensive Cancer Center at the University of Miami Miller School of Medicine and collaborating organizations has identified a next-generation BTK degrader that could help overcome treatment resistance in chronic lymphocytic leukemia (CLL) and related blood cancers.
Their findings, published February 2 in the journal Science, could offer a therapeutic option for CLL patients whose tumors become drug-resistant or are unresponsive to frontline treatment.
For this study, Justin Taylor, M.D. and colleagues, including first author Skye Montoya, a graduate student in his research lab, Omar Abdel-Wahab, M.D., from Memorial Sloan Kettering Cancer Center, and other collaborators assessed the new compound in laboratory studies and a phase 1 clinical trial involving patients with tumors that had become drug-resistant or were unresponsive to therapy. Developed by Nurix Therapeutics, the compound, called NX-2127, is constructed with two modules – one that binds to BTK and another that degrades and eliminates it. Thus, the term BTK degrader.
The researchers reported that NX-2127 efficiently destroyed its cellular targets in both petri dishes and patient cells. “More specifically, this compound destroyed BTK cells in tumors resistant to currently used BTK inhibitors, while shrinking tumors in 11 of 14 CLL patients participating in our study,” said Abdel-Wahab, who was co-corresponding author with Taylor.
One patient, in particular, had an impressive response to this BTK degrader, Taylor and Abdel-Wahab noted. The elderly man had been on pirtobrutinib for two years, but became resistant to it as well as other therapies, leaving him with no other conventional options.
However, while taking NX-2127 during the trial, his symptoms and quality of life improved to where he no longer needed transfusions for anemia, they said.
Although this study had a September 2022 data cutoff for the Science publication, the researchers provided an update this past December at the American Society of Hematology meeting. Overall, 41% of CLL patients responded to NX-2127 and the elderly man was still responding favorably to the drug.
Additionally, the research showed that drug resistance can occur when BTK acquires mutations that give it an entirely new function. These mutations cause BTK to operate as a “scaffold” that recruits other cellular molecules to keep B cells alive.
Most importantly, NX-2127 appears to overcome resistance caused by virtually all of the BTK mutations identified to cause resistance to available BTK inhibitors.
Sylvester Comprehensive Cancer Center release on Newswise